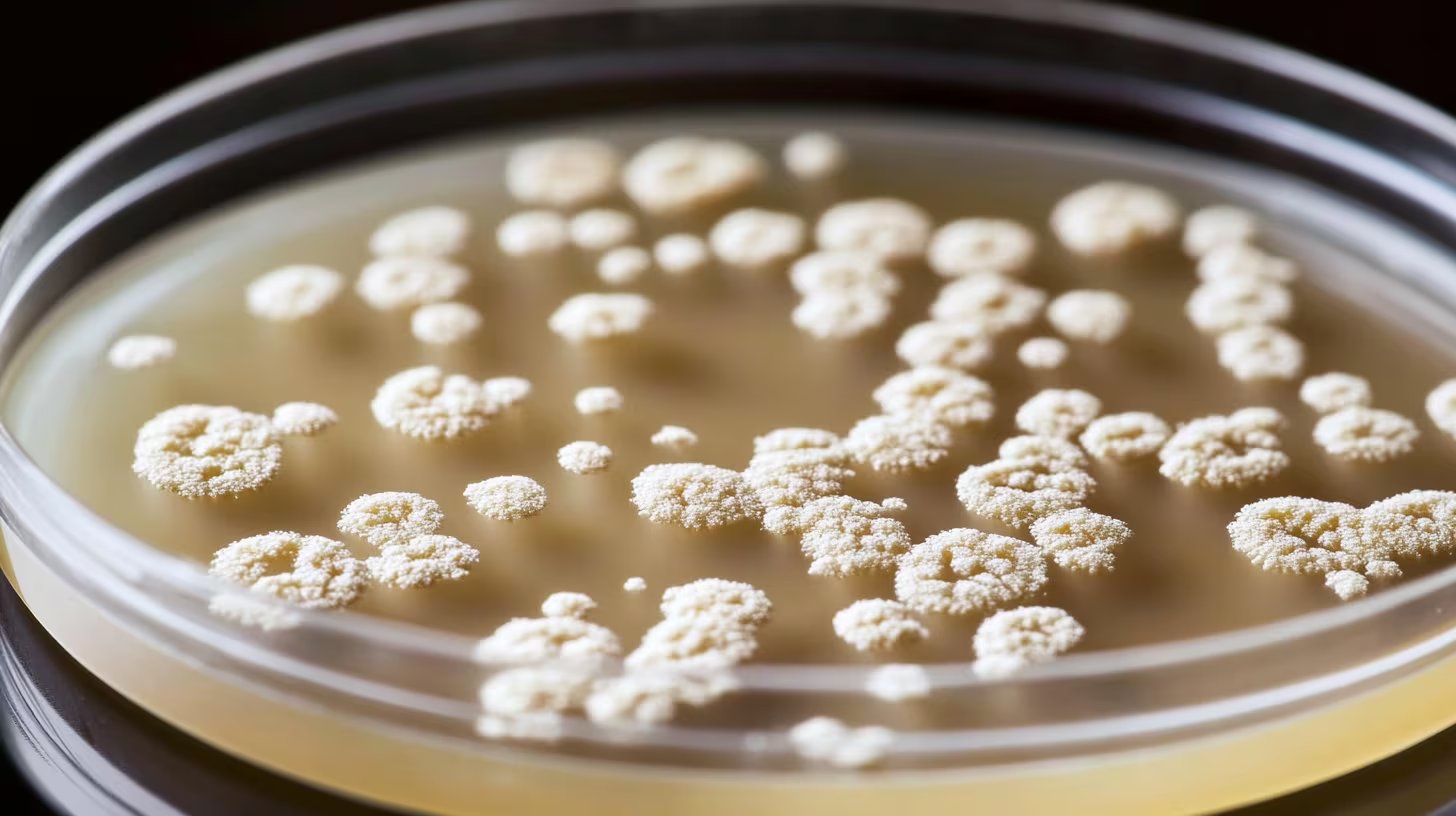
La resistencia antimicrobiana es una amenaza silenciosa para la salud humana y animal
(Imagen Ilustrativa Infobae)

Un descubrimiento sin precedentes en las capas de hielo profundas de la cueva de Scărișoara, en Rumania, ha puesto en alerta a la comunidad científica internacional. Se trata de una superbacteria de 5.000 años de antigüedad que ha demostrado una sorprendente capacidad para sobrevivir ante diez clases de antibióticos modernos.
Este hallazgo, cuyos pormenores fueron divulgados a través de la revista especializada Frontiers in Microbiology, revela no solo los peligros latentes asociados al cambio climático, sino también una oportunidad invaluable para el desarrollo de la biotecnología contemporánea.
La investigación fue encabezada por un grupo de expertos bajo la dirección de Cristina Purcarea, perteneciente al Instituto de Biología de Bucarest de la Academia Rumana. Para obtener la muestra, los especialistas realizaron una perforación en la denominada Gran Sala de la cueva, extrayendo un núcleo de hielo a 25 metros de profundidad. Allí permaneció congelada la cepa bacteriana identificada como Psychrobacter SC65A.3 durante cinco milenios.
Al profundizar en el estudio de su estructura genética, los científicos lograron mapear más de 100 genes de resistencia a diversos fármacos antimicrobianos dentro de este microorganismo ancestral.
Este hallazgo expone datos cruciales sobre las raíces históricas de la resistencia bacteriana y genera preocupación por la salud pública mundial. Los expertos enfatizan que, conforme las temperaturas globales aumentan y el deshielo se acelera por el cambio climático, existe el riesgo inminente de que microorganismos que han estado aislados por siglos puedan emerger nuevamente a la superficie.
Sobre la relevancia de este suceso, la doctora Daniela Hozbor, quien se desempeña como investigadora principal del Conicet en el Instituto de Biotecnología y Biología Molecular (IBBM) de la Universidad Nacional de La Plata, comentó:
“Es un estudio interesante, la resistencia a los antimicrobianos (RAM) es realmente un problema grave para nuestra salud y calidad de vida».

La denominada resistencia microbiana o resistencia a los antimicrobianos (RAM) representa un fenómeno biológico donde agentes como bacterias, virus, hongos y parásitos crean defensas contra los medicamentos diseñados para combatirlos. Esto incluye el fracaso terapéutico de antibióticos, antivirales, antifúngicos y antiparasitarios.
Según explicó Hozbor, esta condición anula la eficacia de los tratamientos médicos, derivando en infecciones que no remiten y elevando las tasas de mortalidad. Para dimensionar la magnitud del problema, la especialista citó cifras de una investigación de The Lancet publicada en 2024:
“en 2021 alrededor de casi 5 millones de muertes estuvieron asociadas a la resistencia a los antimicrobianos de origen bacteriano”.
Un patógeno ancestral frente a la farmacología moderna
Durante los ensayos de laboratorio, se puso a prueba la resistencia de la bacteria frente a una batería de 28 fármacos diferentes. Los resultados confirmaron que el microorganismo neutralizó medicamentos críticos como la rifampicina, la vancomicina y la ciprofloxacina.
Resulta especialmente alarmante que, por primera vez en el género Psychrobacter, se detectara inmunidad ante el metronidazol, la clindamicina y el trimetoprim, medicamentos que se utilizan habitualmente para tratar cuadros infecciosos en la piel, vías respiratorias y sistema urinario.
Esta superbacteria funciona como un depósito genético excepcional adaptado a condiciones de frío extremo.

El equipo de investigación advierte sobre la posibilidad real de que estos genes de resistencia se transfieran a las bacterias que circulan actualmente si el deshielo liberara a estos agentes antiguos. Cristina Purcarea advirtió con claridad sobre este escenario:
“Por un lado, si el deshielo libera estos microbios, sus genes podrían propagarse a las bacterias actuales, agravando la crisis de resistencia”.
A pesar del riesgo de nuevas infecciones de difícil tratamiento, el descubrimiento también abre puertas a la esperanza en el ámbito de la innovación biotecnológica. El genoma de la Psychrobacter SC65A.3 posee aproximadamente 600 genes con funciones aún no descifradas y 11 genes con capacidad potencial para frenar a otros virus, hongos y bacterias.
De acuerdo con Purcarea, estos organismos
“producen enzimas únicas y compuestos antimicrobianos que podrían inspirar la creación de nuevos antibióticos e innovaciones biotecnológicas”
, lo que podría derivar en terapias novedosas contra patógenos que hoy son imbatibles.
Las cuevas de hielo, tales como Scărișoara, se confirman como depósitos de una diversidad genética microbiana aún por explorar, lo que ofrece un vasto campo para la medicina del futuro. No obstante, los expertos insisten en la necesidad de aplicar protocolos de bioseguridad extremadamente estrictos al trabajar con estos organismos para evitar cualquier filtración genética accidental.
La doctora Hozbor recordó que, aunque la mortalidad por este fenómeno varía según la región o la edad, es un desafío de escala mundial que demanda una respuesta inmediata. La interconexión global facilita que estos gérmenes se propaguen con rapidez, por lo cual es vital robustecer los sistemas de vigilancia epidemiológica y los servicios de salud, especialmente en zonas desfavorecidas.
Asimismo, se hizo un llamado a evitar la automedicación y reducir la prescripción excesiva de antibióticos, factores que impulsan la evolución de estas superbacterias.
La vacunación como herramienta de control
En este escenario, la doctora Hozbor resaltó que las inmunizaciones juegan un papel fundamental para frenar la crisis.
“Las increíblemente desprestigiadas vacunas emergen como una de las intervenciones más estratégicas. No solo protegen a la persona vacunada, sino que, al prevenir infecciones, reducen drásticamente la necesidad de usar antibióticos, cortando de raíz la oportunidad de seleccionar microorganismos resistentes”.
Finalmente, la experta enfatizó que la clave reside en una acción conjunta: vigilancia constante, uso responsable de fármacos y fomento de la vacunación. Para Hozbor, esto
“debería ser un contrato social para protegernos y mejorar nuestra calidad de vida y posibilidad de desarrollo”
.
Por su parte, la Organización Panamericana de la Salud (OPS) clasifica como ultrarresistentes a aquellos microorganismos que evaden la mayoría de los medicamentos, lo que perpetúa las infecciones y complica su erradicación en la población.
Fuente: Fuente

